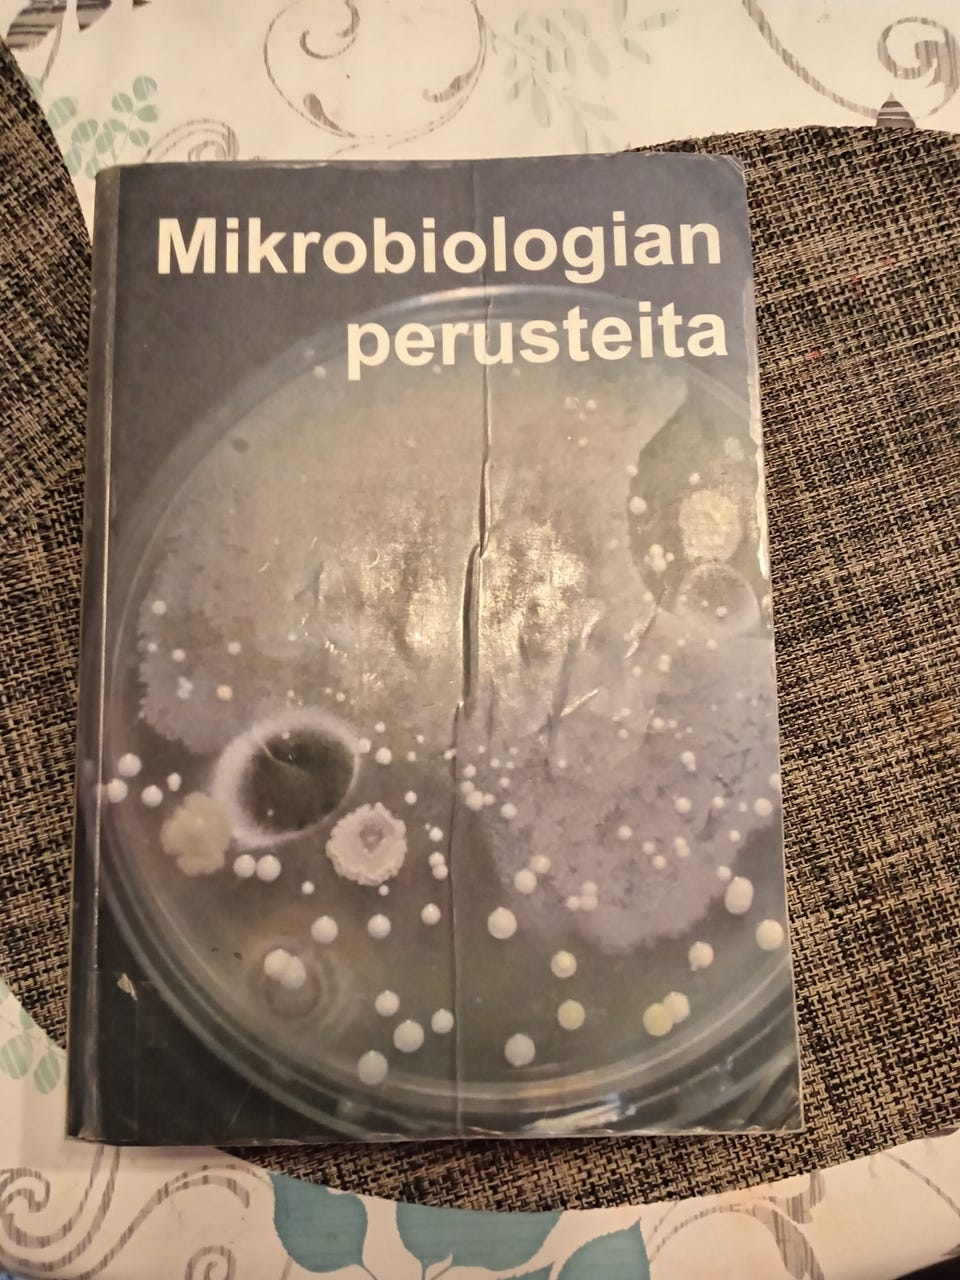
Kuvagalleria

Kuvagalleria
(1/3)
Mikrobiologian perusteita
Myydään
ToriDiili
15 €
Toimitus alkaen 2,99 € + ToriDiili-palvelumaksu 2 €
Shoppaile ToriDiilillä kuin verkkokaupassa
ToriDiili on Torin uusi maksu- ja kuljetuspalvelu. Toimituksen jälkeen sinulla on 24 tuntia aikaa tarkastaa tuote ennen kuin rahat siirretään myyjälle.
Tuotteen kuvaus
Kunto: Kohtalainen
Aihe: Biologia
Käytin tätä kirjaa sairaanhoitajan opinnoissa mutta yleispätevä kirja varmasti muutenkin.
Huom! Painike, joka näyttää koko kuvauksen on pelkästään visuaalinen.
Käyttäjäprofiili

Kirjaudu sisään, jos haluat nähdä profiilin ja lähettää viestejä.
Kirjaudu sisäänIlmoituksen metatiedot
Viimeksi muokattu: 12.11.2025 klo 10.58 ・ Ilmoituksen tunnus: 33041389